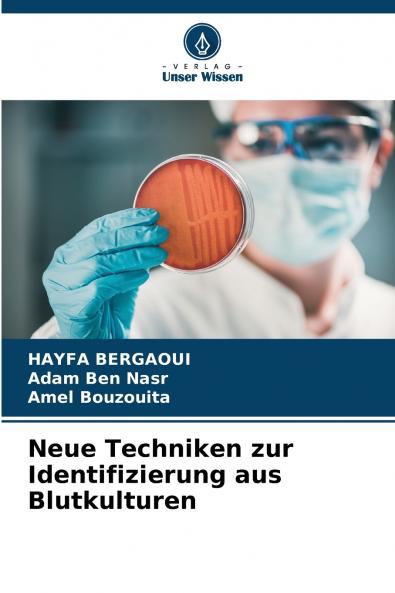
Neue Techniken zur Identifizierung aus Blutkulturen

German
Paperback
₹6400
₹8695
26.39% OFF
(All inclusive*)
Delivery Options
Please enter pincode to check delivery time.
*COD & Shipping Charges may apply on certain items.
Review final details at checkout.
Looking to place a bulk order? SUBMIT DETAILS
About The Book
Description
Author(s)
Bakteriämie ist die häufigste Todesursache auf Intensivstationen. Durch die Entwicklung schneller Methoden kann die Sterblichkeit aufgrund von Verzögerungen bei der angemessenen Antibiotikatherapie gesenkt werden. Matrix-Assisted Laser Desorption Ionization Time-Of-FlightPolymerasekettenreaktion und Fluoreszenz-in-situ-Hybridisierung sind die wichtigsten Techniken die verwendet werden. Flüssigchromatographie gekoppelt mit Tandem-Massenspektrometrie Gaschromatographie gekoppelt mit einem Ionenmobilitätsspektrometer und ImmulexTM sind seltener verwendete Identifizierungstechniken. Real-time video imagingFASTinov®das Uro4 HB&LTM System Fluorogene Sonde das Direct & Rapid Antimicrobial Susceptibility Test SystemScattered Light Integrated Collection. Die Kenntnis der Leistungsfähigkeit der verwendeten Methoden ist für ihre Beherrschung und Zuverlässigkeit unerlässlich. Die Anwendung dieser Techniken im Labor muss sorgfältig auf eine Reihe von Faktoren abgestimmt werden darunter das Krankenhaus die Laborkapazitäten die Kliniker und die Patientenpopulation.
Delivery Options
Please enter pincode to check delivery time.
*COD & Shipping Charges may apply on certain items.
Review final details at checkout.
Details
ISBN 13
9786208229788
Publication Date
-25-10-2024
Pages
-76
Weight
-116 grams
Dimensions
-152x229x4.62 mm